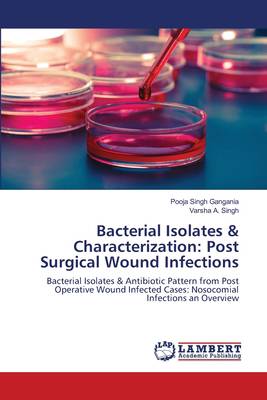

- Afhalen na 1 uur in een winkel met voorraad
- Gratis thuislevering in België vanaf € 30
- Ruim aanbod met 7 miljoen producten
- Afhalen na 1 uur in een winkel met voorraad
- Gratis thuislevering in België vanaf € 30
- Ruim aanbod met 7 miljoen producten
Zoeken
Bacterial Isolates & Characterization: Post Surgical Wound Infections
Bacterial Isolates & Antibiotic Pattern from Post Operative Wound Infected Cases: Nosocomial Infections an Overview
Pooja Singh Gangania, Varsha A. Singh
Paperback | Engels
€ 49,95
+ 99 punten
Omschrijving
Post-operative wound infections have been found to pose a major problem in the field of surgery for a long time and it includes the wounds that drain purulent material, with bacteria identified on culture. Wound infection results from microbes flourishing in the surgical site because of poor preoperative preparation, wound contamination, poor antibiotic selection, or the inability of an immunocompromised patient to fight off infection. The common bacterial isolates includes E coli, Staphyalococcus aureus, Pseudomonas aeruginosa, Klebsiella, Proteus, Enterococcus and Streptococcus . Gram negative organisms are now known to cause more post surgical nosocomial infections then gram positives. Several years of study shows an increasing resistance for drugs that were considered as the first line of treatment for post-operative wound infections. First generation of Cephalosporins and most of the Aminoglycosides including some penicillin are now active against gram positive bacteria whereas successive generations of cephalosporins are found to be active for gram negative organisms.
Specificaties
Betrokkenen
- Auteur(s):
- Uitgeverij:
Inhoud
- Aantal bladzijden:
- 72
- Taal:
- Engels
Eigenschappen
- Productcode (EAN):
- 9783659267499
- Verschijningsdatum:
- 11/03/2014
- Uitvoering:
- Paperback
- Afmetingen:
- 150 mm x 220 mm
- Gewicht:
- 118 g

Alleen bij Standaard Boekhandel
+ 99 punten op je klantenkaart van Standaard Boekhandel
Beoordelingen
We publiceren alleen reviews die voldoen aan de voorwaarden voor reviews. Bekijk onze voorwaarden voor reviews.